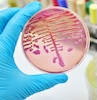
Microbio & Public Health 100x100 Microbio & Public Health

Streamline Study | Banish Burnout | ACE Your Exams!
Testimonials

This is so far my best investment ever. Totally worth the price, content and quality.

Your notes are just awesome, so concise, I just loved them, thank you so much!

I just LOVED these notes i bought! My money was VERY well spent! Im so happy!

I am absolutely happy these notes are amazing!!!!! I recommend to everyone in healthcare!!!!

These notes are AMAZING! Thank you so much!

I am so happy with the purchase, thanks a lot, love it!

These are 100% awesome for your studies, thanks MedStudentNotes!

Awesome! I actually bought the whole bundle last night. The material is incredible!

Your notes are clear, concise, of extreme precision and very easy to read. THANK YOU to your team!

Paid for, received, and downloaded straight away. Excellent quality. thank you.
Need more social proof? Visit our Testimonials page.
Frequently Asked Questions
Got more questions? Visit our FAQ page.